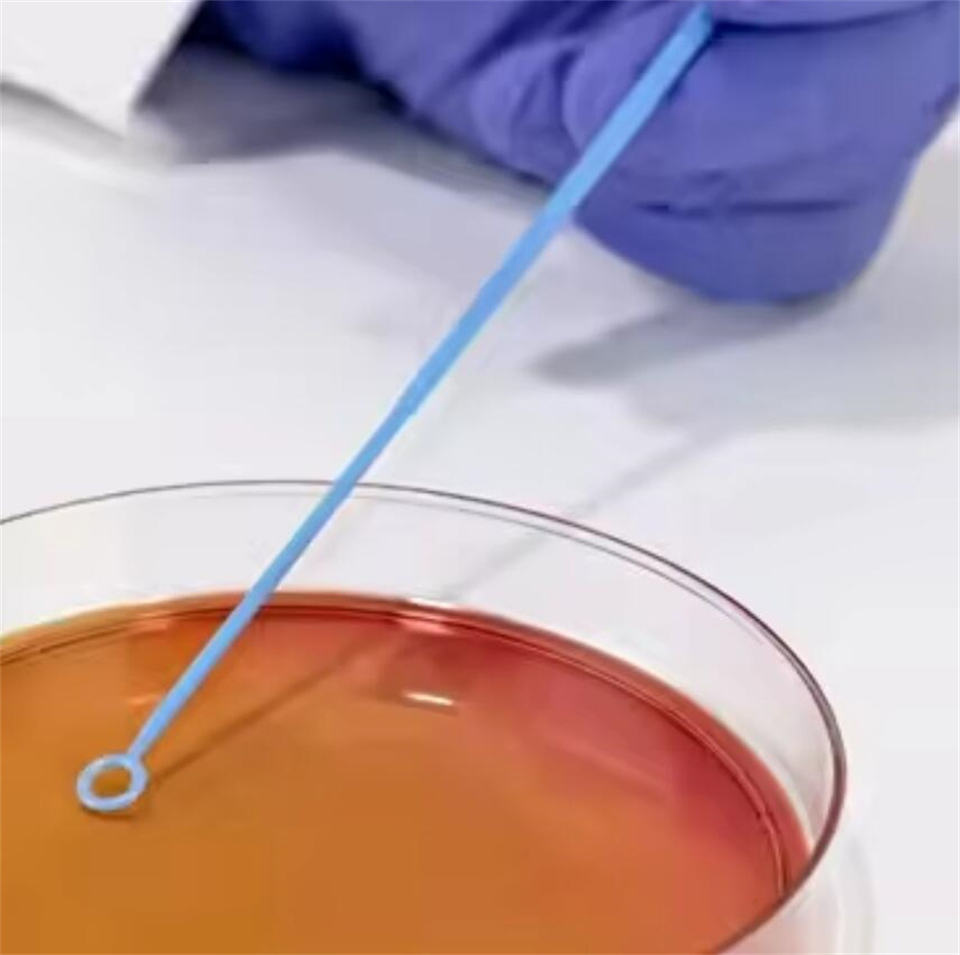

Mọi khoản thanh toán bạn thực hiện trên Alibaba.com đều được bảo mật bằng mã hóa SSL nghiêm ngặt và giao thức bảo vệ dữ liệu PCI DSS

Yêu cầu hoàn tiền nếu đơn hàng của bạn không được vận chuyển, bị thiếu hoặc giao đến có vấn đề về sản phẩm, cùng với trả hàng miễn phí về kho địa phương nếu bị lỗi